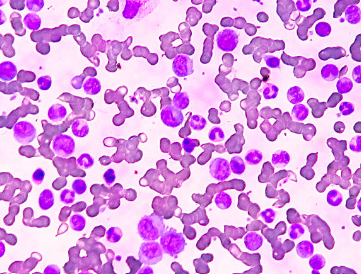

티스토리 뷰
목차

혈소판(Platelet)은 혈액 속에서 혈액 응고를 담당하는 중요한 세포 성분입니다. 혈소판 수치가 정상보다 높아진 상태를 혈소판증가증(Thrombocytosis)이라 하며, 혈액이 지나치게 끈적해져 혈전(피떡)이 잘 생길 수 있습니다.
혈소판 수치 정상 범위

- 성인 기준: 150,000 ~ 450,000/μL
- 이보다 높으면 혈소판 증가증으로 진단될 수 있음
혈소판 수치가 높으면 나타나는 증상



- 두통 – 혈액 점도가 높아지면서 뇌혈류에 영향을 줌
- 어지럼증 – 혈액순환 장애로 인한 증상
- 시야 흐림 – 눈의 미세혈관에 혈류 장애 발생
- 손발 저림 및 통증 – 말초혈관 순환 저하로 발생
- 피부 발적·홍조 – 혈류 장애로 손, 발, 얼굴에 붉은 기운이 나타남
- 혈전 증상 – 다리 통증, 부종, 갑작스러운 호흡곤란, 흉통 등은 심부정맥혈전증(DVT), 폐색전증 가능성을 시사
- 출혈 증상 – 드물지만 혈소판 기능 이상으로 코피, 잇몸 출혈, 멍 발생
혈소판 증가증의 원인



- 일차성(본태성) – 골수에서 혈소판을 과다 생산하는 경우 (골수증식성 질환)
- 이차성(반응성) – 감염, 수술 후, 철결핍성 빈혈, 염증성 질환, 암 등으로 일시적으로 혈소판이 증가
- 기타 요인 – 과도한 스트레스, 만성 출혈, 면역 반응
혈소판 수치 높을 때 위험성



- 혈전증 위험 증가 – 뇌졸중, 심근경색, 폐색전증 위험이 높아짐
- 장기 손상 – 혈액순환 장애로 인해 간, 신장, 뇌 등 장기 기능 저하
- 출혈 위험 – 역설적으로 혈소판이 높아도 혈관 내에서 기능 이상으로 출혈이 생길 수 있음
혈소판 수치 관리 방법



- 혈액검사로 원인 확인 후 전문의 상담
- 혈전 위험이 높은 경우 항혈소판제, 항응고제 치료
- 규칙적인 운동으로 혈액순환 개선
- 수분 충분히 섭취해 혈액 점도 낮추기
- 기름진 음식, 가공식품 줄이고 채소·과일 위주 식단 유지
- 금연·절주로 혈관 건강 관리
혈소판 수치가 높으면 나타나는 증상은 두통, 어지럼증, 시야 흐림, 손발 저림, 피부 발적, 혈전으로 인한 흉통·호흡곤란 등이 있으며, 심하면 심근경색이나 뇌졸중으로 이어질 수 있습니다. 따라서 정확한 원인 진단과 꾸준한 관리가 필수적입니다.
▶ 함께 읽으면 좋을 글 ◀
2025.08.29 - [건강한정보] - 혈소판 수치가 낮으면 나타나는 증상 총정리
혈소판 수치가 낮으면 나타나는 증상 총정리
혈소판은 혈액 속 작은 세포 조각으로, 혈관이 손상되었을 때 출혈을 멈추게 하는 중요한 역할을 합니다. 정상적인 혈소판 수치는 보통 150,000~400,000/㎕ 사이이며, 이보다 낮아지는 상태를 혈소판
mynews0424.com